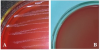
Phân lập và xác định khả năng mẫn cảm với kháng sinh của vi khuẩn gây bệnh bại huyết trên vịt (Riemerella anatipestifer) tại huyện Nam Trực, tỉnh Nam Định

Chào mừng ngày khoa học công nghệ Việt Nam

SINH TRƯỞNG CỦA HỆ SỢI VÀ PHÁT TRIỂN QUẢ THỂ NẤM SÒ VÀNG (Pleurotus cintrinopileatus) TRÊN MỘT SỐ MÔI TRƯỜNG DINH DƯỠNG KHÁC NHAU
- 16/05/2022 09:12:00 AM
- Đã xem: 1026

BƯỚC ĐẦU NGHIÊN CỨU SINH TRƯỞNG, PHÁT TRIỂN CỦA CHỦNG NẤM HẮC CHI GANODERMA SUBRESINOSUM (GA-21) ĐƯỢC PHÂN LẬP Ở VIỆT NAM
- 16/05/2022 09:07:00 AM
- Đã xem: 1117

Trung tâm Giáo dục Thể chất và Thể thao tiếp tục đẩy mạnh công tác nghiên cứu khoa học trong năm học mới 2021-2022
- 13/05/2022 04:06:00 PM
- Đã xem: 460

Một số đặc tính sinh học phân tử của virus gây bệnh Leucosis ở gà nuôi tại một số tỉnh phía Bắc Việt Nam
- 13/05/2022 03:12:00 PM
- Đã xem: 1417

Tỷ lệ nhiễm Mycoplasma hyorhinis ở lợn tại một số huyện ở tỉnh Hưng Yên
- 13/05/2022 03:02:00 PM
- Đã xem: 1179

Nghiên cứu ảnh hưởng của chất lượng tinh lợn sau giải đông đến hiệu quả tạo phôi trong ống nghiệm
- 13/05/2022 02:47:00 PM
- Đã xem: 666

Sàng lọc và phát triển các nguồn cà chua phục vụ chọn tạo giống cà chua ăn tươi chất lượng cao Baby Socola
- 13/05/2022 02:42:00 PM
- Đã xem: 629

Sự lưu hành của Rotavirus gây tiêu chảy trên đàn bò tại Nghệ An và vùng phụ cận
- 09/05/2022 05:02:00 PM
- Đã xem: 453